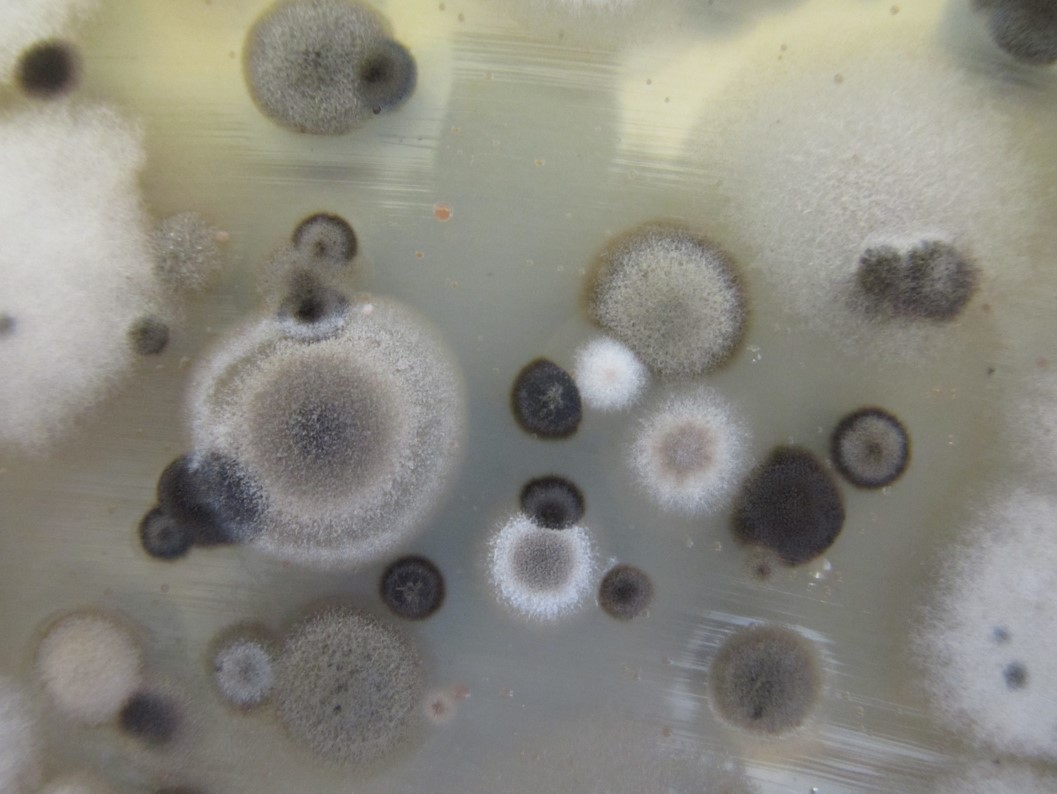
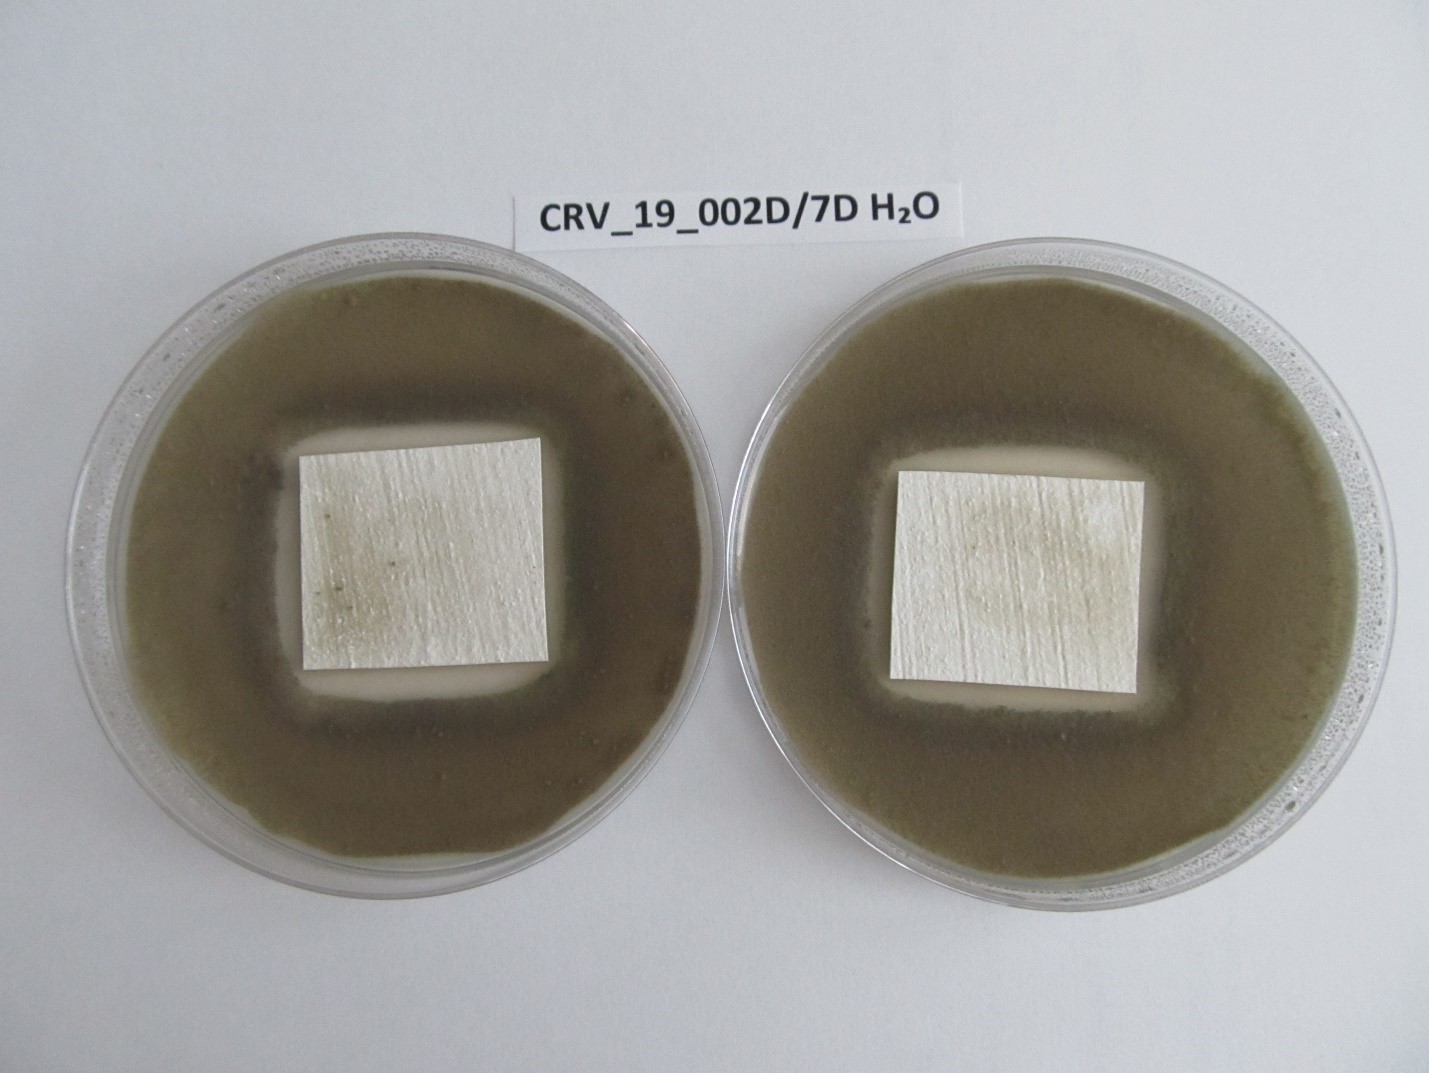

Néhány lakásban, annak ellenére, hogy a probléma általánosan ismert és a kivitelezési munkálatokat helyesen végezték el, még mindig megjelenik a penész, amely erősen negatívan befolyásolja az életminőséget. A penész tevékenysége hatással lehet az emberek közérzetére, a szennyezett felületek esztétikájára, és súlyosabb esetekben még bizonyos anyagok minőségére is. Ezen kívül a penész a mikroklímát is befolyásolja azokban a helyiségekben, ahol erőteljesen elszaporodott.
Amíg a lakásban nincsenek nagyobb hibák a szerkezetben, a hőszigetelésben és a vízszigetelésben, általában kis erőfeszítéssel már könnyen megszűntethető a penész. Fontos megérteni, hogy mi a penész, mire van szüksége a kialakulásához, és mi a legmegfelelőbb megoldás ellene.
A penész növekedéséhez és fejlődéséhez szerves és ásványi tápanyagokra, vízre és megfelelő hőmérsékletre van szüksége, amely általában megegyezik a szobahőmérséklettel. A spórák levegőben terjednek, és a megfelelő felületeken kicsíráznak, majd fokozatosan elterjednek.
A falon megjelenő penész nemcsak az otthon esztétikai megjelenését rontja, hanem egészségünkre is káros hatással lehet. A penésszel közvetlen érintkezés, illetve a spórák belélegzése különböző tüneteket válthat ki. A leggyakoribbak közé tartoznak az allergiás reakciók, amelyek az orrban, a szemekben és a torokban jelentkezhetnek, és gyakran megfázásként értelmezik őket. További lehetséges tünetek: láz, fejfájás, szédülés, asztma, bőrgyulladás, valamint ízületi fájdalmak.
A víz jelenléte
Általában három ok állhat a penész megjelenésének hátterében:
- Kisebb hibák a hőszigetelésben, amelyek hidegebb felületeket eredményeznek a falakon,
- Nem megfelelő légáramlás, ami kapilláris páralecsapódást okoz,
- Vagy a legnyilvánvalóbb ok, ami a folyóvíznek való közvetett vagy közvetlen kitettség (fürdőszoba, konyha stb.).

Megoldás a hatékony penészeltávolításhoz
A penész hatékony eltávolításának megoldása a lakásban kétlépcsős kezeléssel érhető el, ahol az első lépésben a penész fizikai eltávolítását végezzük el, majd a falak felületéhez megfelelő anyagokat választunk és alkalmazunk, amelyek vagy megakadályozzák a páralecsapódás kialakulását, vagy gátolják a penész növekedését. Lehetőség van olyan anyagok választására is, amelyek teljesen inert módon viselkednek a biológiai hatásokkal szemben (fürdőszobai csempe, üveg, vagy az innovatív HYDROSOL Decor rendszer). Első lépésben javasolt a penészes felületeket forró/meleg vízzel letisztítani, majd a száradás után ALGICIDE Plus Spray-vel fertőtleníteni, melyet közvetlenül a fertőzött felületekre permetezve kell felvinni, és jobb hatás érdekében puha kefével vagy ruhával átdörzsölni. Hőhidak vagy a nem megfelelő légáramlás okozta problémák megoldásaként a JUBOLIN Thermo és JUPOL Thermo rendszerek használatát javasoljuk. A Thermo rendszer csökkenti a hőátadást a levegőből a falba, így a vízmolekulák kevesebb energiát veszítenek a felülettel érintkezve, ennek eredményeként csökken a páralecsapódás lehetősége.
Sok esetben a fenti megoldás elegendő, különösen, ha figyelünk a helyiség megfelelő szellőztetésére. Amikor az előbbi kezelés nem elegendő, akkor a JUPOL Thermo falfestékhez adagolt JUBOCIDE Plus biocid készítménnyel fokozhatjuk a felület ellenálló képességét. A nem megfelelő légáramlás okozta falszáradási problémát különböző páramentesítő eszközökkel, légkondicionálókkal részben meg lehet oldani, de a lakásban még mindig lehetnek kritikus pontok. Ezek elsősorban olyan felületek, amelyek általában rejtve vannak a szem elől, például szekrények, ágyak és egyéb bútorok mögötti falfelületek. A penészképződés szempontjából ezek a legproblémásabb felületek, melyek egészségünkre is hatással vannak. Viszonylag nagy felülettel rendelkeznek, melyeken a nehezen hozzáférhetőség miatt több por halmozódik fel, így a penész tápanyagforrásául szolgálhat. Ráadásul ezek a felületek rejtve vannak a szemünk elől, ezért nem fordítunk rájuk akkora figyelmet, mint amikor a penész látható helyeken jelenik meg.
A “nehezen hozzáférhető felületek” leghatékonyabb védelme a megelőzés. Festéshez válasszuk a JUPOL Citro penszgátló adalékot tartalmazó falfestéket, vagy más terméket a JUPOL festékcsaládból, melyhez JUBOCIDE Plus penészedést gátló szert adagolunk. A hatékonyabb védelem érdekében a JUPOL Amikol is alkalmazható.
Mivel a biocid anyagok idővel veszítenek hatékonyságukból a festékből alkalmazott rétegek számával a felület védelmének időtartama is növekszik.
Víznek kitett felületek
Vannak olyan bevált, gyakran használt megoldások, amelyek nem alkalmazhatók minden felületen, például sima, nem nedvszívó felületeken, mint az üveg, a kerámia és hasonlók. Az ilyen típusú megoldásokat rendszerint konyhai pultok felett és olyan helyiségekben használják, ahol a víz hatása nagyobb, például fürdőszobákban, szaunákban, zuhanyzókban és hasonló környezetben.
Ezek olyan felületek, ahol a falak nedvesedését és a víz megjelenését nem lehet megakadályozni, vagy pont erre a célra szolgálnak. A kerámia, üveg és hasonló burkolatok azonban nem adnak „teljes szabadságot” a megjelenés, textúra, szín és más esztétikai paraméterek terén, mint más falburkolatok. Ezek a burkolatok általában fürdőszobákban vagy konyhapultoknál használatosak, és az egyes burkolati elemek közötti illesztések, fugák és dilatációk továbbra is ki vannak téve a fertőzésnek.
Alternatív megoldást jelenthet egy olyan burkolat, amelyek kémiailag és mechanikailag rendkívül ellenálló, ezért olyan helyeken is alkalmazhatók, ahol a kerámiacsempe a megszokott. Fürdőszobák vagy konyhák burkolásához használható a HYDROSOL Decor rendszer, melynek egyik eleme HYDROSOL Decor Base dekoratív vizzáró anyag, mely a falfelületek kezelésére szolgál, és/vagy a HYDROSOL Decor Floor, mely a falak mellett a padlóra is alkalmazható. Végső bevonatként HYDROSOL Polyurethane 2K lakkot használunk, amely a dekoratív felületek számára teljes vízvédelmet és mechanikai szilárdságot biztosít, így még zsíroldók és vízkőoldók is használhatók a tisztítás során. A zárt felület nem engedi, hogy a víz beszivárogjon a falba, így gyorsabban lefolyik és hamarabb szárad.
A 2k PU fedőréteg lényege a magas kémiai térhálósodás, amely egyedi mechanikai tulajdonságokat ad a fedőrétegnek, így semmi nem hatol bele és teljesen ellenálló a penészmicéliummal szemben. Ez a védelem a kerámia és üvegfelületekhez hasonlóan általában elegendő a penészgombák szaporodásának megakadályozására. Ha azonban az ilyen felületeket hosszú ideig érintetlenül hagyjuk, akkor a felület szennyeződik és a magas páratartalom miatt hosszú távon itt is előfordulhat penészesedés, ami szerencsére nem jelent problémát. Ezen a felületen megjelenő penész egyszerűen lemosható, ami után a felület teljesen helyreáll, és nem igényel további biocid készítményekkel való kezelést.